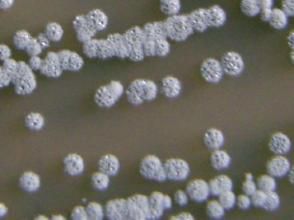
微黃綠鏈黴菌 微黃綠鏈黴菌

簡介
高氏合成1號瓊脂:氣絲秸草色至微黃綠色,絨狀。基絲無色。無可溶色素。甘油天冬素瓊脂(ISP)、無機鹽澱粉 瓊脂(ISP)、酵母精麥芽精瓊脂(ISP)、燕麥粉瓊脂 (ISP):氣絲淡黃色或微白色。基絲反面淡黃色或淺灰黃 色。可溶色素無或跡量黃色,對pH不敏感。高氏有機2號 瓊脂:氣絲白色或微黃色。基絲無色、微黃色或微褐色。 可溶色素無或微黃色。馬鈴薯塊:氣絲白色或乳脂色。基絲無色。無可溶色素。 明膠液化。牛奶不凝固,但腖化,微黃色素。澱粉水解。 纖維素上生長。硝酸鹽還原。不產生類黑色素、酪氨酸酶 和H2S。利用D—葡萄糖、L—阿拉伯糖、D—木糖;對D— 果糖、蔗糖、鼠李糖、肌醇的利用,報導分歧;不利用棉子糖、D—甘露醇。抑制革蘭氏陽性細菌。盤點鏈黴菌微生物系列(十二)
| 真菌(fungus;eumycetes)是具有真核和細胞壁的異養生物。種屬很多,已報導的屬達1萬以上,種超過10萬個。其營養體除少數低等類型為單細胞外,大多是由纖細管狀菌絲構成的菌絲體。本期為第十二期。 |